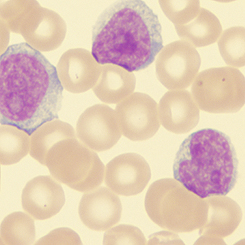

|
||||
| The Institute | Research & Education | Programs | AngioNews/Media | Partnerships |

Welcome to the AngioInstitute
Supporting Diagnostic Innovations and Non-Invasive Global Health
The AngioInstitute—also known as the Institute for Global Health Innovations—is a nonprofit research, education, and advocacy hub advancing the future of diagnostic science and image-guided medicine.
Founded in 2001 and relaunched in 2018, we support physicians, scientists, and health-technology innovators in solving complex clinical challenges through non-invasive imaging, precision diagnostics, and validated therapeutic innovation. Our work accelerates the development, testing, and adoption of safer, more effective tools that improve patient outcomes.
Today, the AngioInstitute operates as a collaborative global network, funding and supporting:
-
Clinical research and validation studies
-
Physician education and advanced imaging training
-
Public health education and awareness initiatives
-
Cross-disciplinary partnerships with medical and health-technology innovators
We champion non-invasive, image-guided solutions that improve early detection, guide treatment decisions, and reduce unnecessary interventions—while remaining accessible, scalable, and patient-centered. At our core, we are a community-driven organization committed to education, collaboration, and shared progress. Through symposiums, training programs, and open knowledge exchange, we help move medicine forward—empowering clinicians to see more clearly, act more precisely, and care more compassionately.
Uniting Sciences for Improved Access to Solutions
 |
The AngioInstitute is committed to uniting science, technology, and clinical leadership to accelerate access to meaningful health solutions. We believe that progress happens fastest when disciplines collaborate—when innovators, clinicians, researchers, and decision-makers work together toward shared outcomes that serve the public good.
Our role is to bridge silos across medical specialties, diagnostic modalities, and emerging technologies. By fostering strategic partnerships and collaborative alliances, the AngioInstitute helps validate, integrate, and scale non-invasive diagnostic and therapeutic solutions that address real-world clinical and community needs. This includes aligning imaging, data-driven diagnostics, integrative therapies, and educational platforms into cohesive care strategies.
Through consortium building, pilot programs, and multi-institutional initiatives, we support the translation of innovation into practice—reducing barriers related to cost, access, and awareness. Our work prioritizes solutions that are safe, evidence-informed, and adaptable across diverse healthcare settings, from advanced medical centers to community-based programs. By uniting sciences and stakeholders around shared standards and purpose, the AngioInstitute accelerates the path from discovery to delivery—ensuring that effective, forward-thinking healthcare solutions reach the people and populations who need them most.
Research & Educational PROGRAMS
The AngioInstitute has been recognized worldwide by official medical organizations and peer reviews for its work in FIVE MAIN focal topics and class divisions. We continually maintain and update research works in these categories to support the advancement of these disciplines as part of The AngioInstitute's commitment to the scientific community.
DIAGNOSTIC PROGRESS: Global support of the advanced use of modern Diagnostic Imaging technologies to identify all health issues - including the development of new protocols and the support of new modalities. DIAGNOSTIC PROGRESS: Global support of the advanced use of modern Diagnostic Imaging technologies to identify all health issues - including the development of new protocols and the support of new modalities. |
 PUBLISHING all findings, reviews and direct-from- professional field research about all therapeutic and diagnostic processes. Academic exchange through web-based distribution for the medical and patient communities. PUBLISHING all findings, reviews and direct-from- professional field research about all therapeutic and diagnostic processes. Academic exchange through web-based distribution for the medical and patient communities. |
 TECH REVIEW: Beta-testing, industry-wide comparative feature review/evaluation program. Evaluation of upcoming designs entering the public market leading to an independent public report of all non-invasive medical and health innovations. TECH REVIEW: Beta-testing, industry-wide comparative feature review/evaluation program. Evaluation of upcoming designs entering the public market leading to an independent public report of all non-invasive medical and health innovations. |
 OCCUPATIONAL HEALTH HAZARDS: Internal study of all work-related illnesses including chronic disorders and predispositions from victims associated with all first responders exposed to disaster-related rescue calls. Collaboration environmental statistics. OCCUPATIONAL HEALTH HAZARDS: Internal study of all work-related illnesses including chronic disorders and predispositions from victims associated with all first responders exposed to disaster-related rescue calls. Collaboration environmental statistics. |
 EXPLORATORY LAB SCIENCE: Case studies of domestic and foreign health solutions of all laser-based medical equipment including devices specializing in sub-dermal musculatory treatment of chronic disorders. EXPLORATORY LAB SCIENCE: Case studies of domestic and foreign health solutions of all laser-based medical equipment including devices specializing in sub-dermal musculatory treatment of chronic disorders. |
 |
ABOUT OUR FOUNDER
Robert L. Bard, MD: A Visionary for Smarter Health Solutions
As a diagnostic imaging specialist and philanthropist, Dr. Bard has dedicated his career to advancing non-invasive technologies that make healthcare safer, more precise, and more accessible. His life’s work is defined by a steadfast belief in independent thinking, scientific curiosity, and visionary leadership in medicine.
Dr. Bard is widely recognized for his pioneering work in advanced ultrasound, Doppler imaging, and image-guided diagnostics, particularly in cancer and chronic disease management. His commitment to non-invasive approaches reflects a clear mission: reduce patient risk, lower healthcare costs, and enable real-time clinical insight that empowers earlier and better decision-making.
Beyond clinical innovation, Dr. Bard is a passionate advocate for global education and awareness. He actively supports physician training, public health education, and professional societies worldwide—believing that knowledge shared is innovation multiplied. Central to this mission is his commitment to fundraising and digital publishing, ensuring that research, clinical insights, and emerging technologies are accessible to communities, clinicians, and innovators alike.
Through leadership, education, and generosity, Dr. Bard continues to shape a more informed, compassionate, and forward-thinking future for medicine.
 |
Global Education & Public Empowerment
The AngioInstitute is a nonprofit organization dedicated to advancing global health education, clinical advocacy, and research focused on non-invasive diagnostic and therapeutic solutions for chronic disease and cancer. Our mission is to equip communities and clinicians worldwide with the knowledge needed to prevent illness, improve early detection, and support safer, more effective care. We champion forward-thinking, integrative, and functional health strategies that complement conventional medicine and expand the spectrum of prevention and treatment options. Education is our primary vehicle for change.
Core Global Education Initiatives include:
• Educational outreach and presentations on cancer prevention and chronic disease awareness, tailored to social, occupational, and cultural communities
• Publishing research findings, technology performance reviews, and clinical insights on emerging non-invasive health solutions
• Delivering public lectures, workshops, and training programs through conferences, schools, clinics, and international partner organizations
A central focus of the AngioInstitute is reaching underserved and at-risk populations through targeted education, awareness campaigns, and screening initiatives. By leveraging digital publishing, webinars, virtual summits, and community-based events, we remove geographic and economic barriers to trusted health information. Through strategic partnerships with clinicians, educators, and researchers, the AngioInstitute connects the public to expert guidance and underutilized medical resources—empowering individuals and communities to make informed, proactive decisions about their health and well-being.